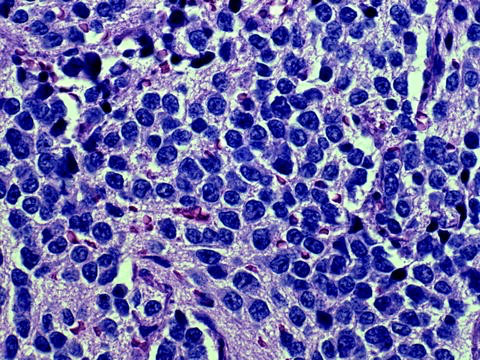

연부조직종양
횡문근육종 (Rhabdomyosarcoma)
정의: 원시 중간엽 세포(primitive mesenchymal cells)에서 기원하여 골격근으로 분화하는 특징을 보이는 악성 연부조직 종양
역학 및 특징
소아에서 가장 흔한 연부조직 육종으로, 전체 소아암의 약 3%를 차지
신체 어느 부위에서나 발생 가능하지만, 주로 두경부, 비뇨생식기계, 사지에서 호발
혈액, 림프절 전이 가능 → 폐, 뼈, 골수, 림프절, 중추신경계(뇌막 주변) 등 전이
연관 유전 증후군
리-프라우메니 증후군 (Li-Fraumeni syndrome): TP53 유전자 변이
신경섬유종증 1형 (Neurofibromatosis type 1): NF1 유전자 변이
베크위트-비데만 증후군 (Beckwith-Wiedemann syndrome)
코스텔로 증후군 (Costello syndrome)
누난 증후군 (Noonan syndrome)
임상양상
빠르게 커지는 종괴 (통증 동반 하기도 하고 안하기도함)
종양 발생위치에 따른 증상
코인후부: 코울혈, 구강호흡, 코피, 연하장애
두개골: 뇌신경마비,시력저하, 뇌압상승증상
얼굴, 뺨, 경부: 국소 팽만, 개구장애, 신경증상, 안구돌출/안검하수, 기침
중이: 통증, 청력저하, 만성 이루, 귓속의 종괴
몸통, 사지: 외상 후 발견되는 종괴가 지속되거나 커짐
비뇨생식기:혈뇨, 하부 비뇨기 폐쇄, 반복성 UTI, 폐쇄 증상
전이 증상: 호흡곤란 (폐전이), 고칼슘혈증 (광범위 뼈전이)
진단
영상검사: CT/MRI, 흉부CT (폐전이 확인), 뼈 스캔/PET CT
좌: retroperitoneal rhabdomyosarcoma
우: paraspinal rhabdomyosarcoma조직생검 (절개생검 또는 바늘생검)
small round blue cell tumor
면역조직화학검사: 횡문근 항원 (desmin, muscle specific actin, myogenin) → 확진
치료
다학제적 접근 필요
항암화학요법 → 외과적 절제 → 보조항암요법/방사선치료
regimen: Vincristine, Actinomycin-D, Cyclophosphamide
(고위험군에서는 Ifosfamide, etoposide, doxorubicin 등 추가)
[1] 홍창의 12e, pg. 997-1000
[2] Nelson’s pediatrics, 22e. pg. 3136-3138
연습문제 7문제
0/7 완료
1개의 글
** 제목만 보더라도 어떤 내용인지 알 수 있도록 완성된 문장으로 작성해주세요.
예시) 초음파 (X) → 초음파 사진에서 PDA 소견을 어떻게 알 수 있나요? (O)